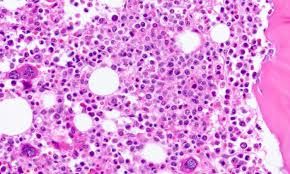
Bệnh niemann-Pick - Triệu chứng, nguyên nhân và cách điều trị

Bệnh niemann-Pick - Triệu chứng, nguyên nhân và cách điều trị
Bệnh Niemann-Pick là một nhóm các bệnh di truyền trong gia đình làm cho chất béo được gọi là lipid tích tụ trong các tế bào của lách, gan và não. Để hiểu rõ hơn về bệnh lý này, mời các bạn tham khảo bài viết dưới đây.
Mục lục nội dung
1. Tìm hiểu chung
Bệnh Niemann-Pick là một nhóm các bệnh di truyền trong gia đình làm cho chất béo được gọi là lipid tích tụ trong các tế bào của lách, gan và não.
Có 3 hình thức phổ biến của bệnh:
- Loại A ;
- Loại B ;
- Loại C.
Mỗi loại liên quan đến các cơ quan khác nhau, có thể có hoặc không liên quan đến hệ thần kinh và hô hấp. Mỗi loại có thể gây ra các triệu chứng khác nhau và xảy ra vào những thời điểm khác nhau suốt đời.
Niemann-Pick là một bệnh hiếm gặp, có thể xảy ra ở mọi lứa tuổi nhưng chủ yếu ảnh hưởng đến trẻ em. Hãy thảo luận với bác sĩ để biết thêm thông tin.
2. Triệu chứng
Các triệu chứng phổ biến của bệnh Niemann-Pick là:
- Đi lại vụng về và khó khăn;
- Co thắt cơ bắp hoặc chuyển động mắt quá mức;
- Rối loạn giấc ngủ Nuốt và ăn khó khăn;
- Viêm phổi tái phát.
Ba loại chính của bệnh Niemann-Pick là loại A, B và C. Các dấu hiệu và triệu chứng phụ thuộc vào thể loại và mức độ nghiêm trọng của tình trạng bệnh. Một số trẻ sơ sinh với loại A sẽ hiển thị các dấu hiệu và triệu chứng trong vòng vài tháng đầu đời. Những trẻ mắc loại B có thể không có dấu hiệu trong nhiều năm và có cơ hội sống sót tốt hơn đến tuổi trưởng thành. Những người bị loại C có thể không gặp bất kỳ triệu chứng nào cho đến khi trưởng thành.
Bạn có thể gặp các triệu chứng khác không được đề cập. Nếu bạn có bất kỳ thắc mắc nào về các dấu hiệu bệnh, hãy tham khảo ý kiến bác sĩ.
Nếu bạn có bất kỳ dấu hiệu hoặc triệu chứng nêu trên hoặc có bất kỳ câu hỏi nào, xin vui lòng tham khảo ý kiến bác sĩ. Cơ địa mỗi người là khác nhau, vì vậy hãy hỏi ý kiến bác sĩ để lựa chọn được phương án thích hợp nhất.
3. Nguyên nhân
Bệnh Niemann-Pick loại A và B xảy ra khi các tế bào trong cơ thể không có enzyme sphingomyelinase axit (ASM). Chất này giúp phá vỡ (chuyển hóa) chất béo sphingomyelin, được tìm thấy trong mọi tế bào của cơ thể.
Nếu enzyme này bị thiếu hoặc không hoạt động đúng, sphingomyelin sẽ tích tụ trong các tế bào. Nó sẽ giết chết các tế bào và cản trở hoạt động của các cơ quan.
Loại A xảy ra ở mọi chủng tộc và sắc tộc. Loại này phổ biến hơn trong nhóm dân Ashkenazi (Đông Âu) Do Thái.
Loại C xảy ra khi cơ thể không chuyển hóa cholesterol và chất béo khác (lipid) đúng cách. Điều này dẫn đến có quá nhiều cholesterol trong gan và lá lách đồng thời quá nhiều chất béo khác trong não.
Loại C1 là một biến thể của loại C. Đột biến của loại này can thiệp vào cách cholesterol di chuyển giữa các tế bào não. Loại này chỉ thấy ở những người Canada gốc Pháp ở Yarmouth, Nova Scotia.
4. Chẩn đoán & điều trị
Những kỹ thuật y tế nào dùng để chẩn đoán bệnh Niemann-Pick?
Xét nghiệm máu hoặc tủy xương có thể được thực hiện để chẩn đoán các loại A và B. Xét nghiệm này chỉ hiện thị kết quả với những người có bệnh, nhưng không hiển thị với những người chuyên chở gen bệnh. Xét nghiệm ADN có thể được thực hiện để chẩn đoán những người chuyên chở của loại A và B.
Sinh thiết da thường được thực hiện để chẩn đoán loại C và D. Bác sĩ theo dõi cách các tế bào da phát triển, di chuyển và lưu trữ cholesterol. Xét nghiệm ADN cũng có thể được thực hiện để tìm kiếm 2 gen gây ra loại bệnh này.
Các xét nghiệm khác có thể bao gồm:
- Chọc hút tủy xương;
- Sinh thiết gan (thường là không cần thiết);
- Kiểm tra mắt với đèn khe;
- Các xét nghiệm kiểm tra nồng độ enzyme.
Những phương pháp nào dùng để điều trị Niemann-Pick?
Hiện nay chưa có cách chữa trị hiệu quả cho loại A. Cấy ghép tủy xương có thể được xem xét với loại B. Các nhà nghiên cứu tiếp tục thử nghiệm các phương pháp điều trị khác như thay thế enzyme và liệu pháp gen.
Một loại thuốc mới có tên là miglustat dùng để điều trị các triệu chứng thần kinh loại C.
Cholesterol cao có thể quản lý tốt với chế độ ăn uống lành mạnh ít cholesterol hoặc dùng thuốc. Tuy nhiên, nghiên cứu không cho thấy các phương pháp này ngăn chặn được sự tiến triển của bệnh hoặc thay đổi cách các tế bào chuyển hóa cholesterol. Thuốc giúp kiểm soát hoặc làm giảm nhiều triệu chứng như mất trương lực cơ đột ngột và co giật.
Trên đây là một số thông tin liên quan đến Niemann-Pick, hy vọng bài viết sẽ hữu ích cho các bạn trong quá trình tìm hiểu và điều trị bệnh!



